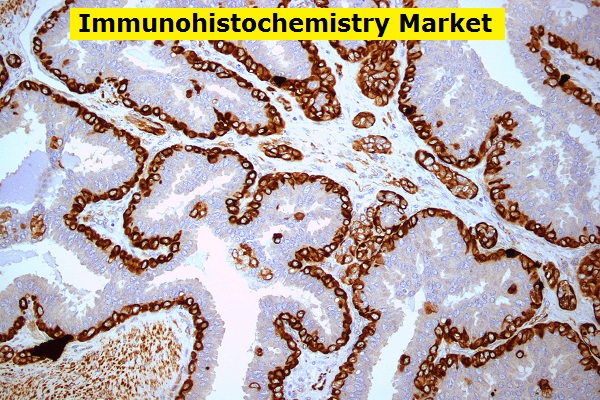

The global biopharmaceutical excipients market size is projected to reach USD 3.0 billion by 2027, exhibiting a CAGR of 5.9%, according to a new report by Radiant Insights, Inc. The demand for biopharmaceutical excipients is anticipated to increase given that several biologicals will be expiring over the next few years. Rapidly evolving development and manufacturingContinue reading “Global Biopharmaceutical Excipients Market Opportunity And Industry Expansion Strategies 2027”
Category Archives: Pharmaceutical
Pharmaceutical Analytical Testing Outsourcing Market : Current Trends, Future Demand, Market Analysis & Outlook To 2027
The global pharmaceutical analytical testing outsourcing market size is expected to reach USD 11.4 billion by 2027, according to a new report by Radiant Insights, Inc., registering a CAGR of 8.3% over the forecast period. Increasing pipelines for biological candidates, rising demand for additional analytical details on drugs, and process development by regulatory agencies areContinue reading “Pharmaceutical Analytical Testing Outsourcing Market : Current Trends, Future Demand, Market Analysis & Outlook To 2027”
Immunohistochemistry Market Growth Analysis, Share, Demand By Regions And Forecast To 2027
The global immunohistochemistry market size is expected to reach a value of USD 3.2 billion by 2027, expanding at a CAGR of 7.8%, according to a new report by Radiant Insights, Inc. Rising prevalence of chronic diseases, increasing regulatory approvals, and launch of technologically advanced immunohistochemistry (IHC) systems are expected to propel market growth overContinue reading “Immunohistochemistry Market Growth Analysis, Share, Demand By Regions And Forecast To 2027”
Biomarkers Market Research Report, Industry Size, Share, Demand, Latest Study, Growth Analysis & Forecast From 2020 To 2027
The global biomarkers market size is expected to reach over USD 129.4 billion by 2027, according to a new study conducted by Radiant Insights, Inc. It is anticipated to exhibiting a CAGR of 13.7%, during the forecast period. Factors, such as increasing collaborations and funds for R&D activities, rising consumer awareness, a widening patient base,Continue reading “Biomarkers Market Research Report, Industry Size, Share, Demand, Latest Study, Growth Analysis & Forecast From 2020 To 2027”
Hard Capsules Market Business Analysis, Scope, Size, Trends, Demand, Overview, Forecast 2028
The global Hard Capsules market was valued at $XX million in 2018, and Radiant Insights, Inc. analysts predict the global market size will reach $XX million by the end of 2028, growing at a CAGR of XX% between 2018 and 2028. This report provides detailed historical analysis of global market for Hard Capsules from 2013-2018,Continue reading “Hard Capsules Market Business Analysis, Scope, Size, Trends, Demand, Overview, Forecast 2028”
Tuberculin Market Analysis, Growth, Consumption, Production Cost, Business Insights, Development Status And Forecast 2028
The global Tuberculin market was valued at $XX million in 2018, and Radiant Insights, Inc. analysts predict the global market size will reach $XX million by the end of 2028, growing at a CAGR of XX% between 2018 and 2028. This report provides detailed historical analysis of global market for Tuberculin from 2013-2018, and providesContinue reading “Tuberculin Market Analysis, Growth, Consumption, Production Cost, Business Insights, Development Status And Forecast 2028”
Hydroxycarbamide Market Size, Share, Growth, Strategies, Trends, Analysis And Forecast To 2028
The global Hydroxycarbamide market was valued at $XX million in 2017, and Radiant Insights, Inc. analysts predict the global market size will reach $XX million by the end of 2028, growing at a CAGR of XX% between 2017 and 2028. This report provides detailed historical analysis of global market for Hydroxycarbamide from 2013-2018, and providesContinue reading “Hydroxycarbamide Market Size, Share, Growth, Strategies, Trends, Analysis And Forecast To 2028”
Vinpocetine Market Outlook, Innovation, Size, Share, Industry Technology And Business Growth Till 2028
The global Vinpocetine market was valued at $XX million in 2017, and Radiant Insights, Inc. analysts predict the global market size will reach $XX million by the end of 2028, growing at a CAGR of XX% between 2017 and 2028. This report provides detailed historical analysis of global market for Vinpocetine from 2013-2018, and providesContinue reading “Vinpocetine Market Outlook, Innovation, Size, Share, Industry Technology And Business Growth Till 2028”
Biosimilar Monoclonal Antibodies Market Size, Share, Demand, Challenges, Growth And Research In Medical Sector 2028
The global Biosimilar Monoclonal Antibodies market was valued at $XX million in 2018, and Radiant Insights, Inc. analysts predict the global market size will reach $XX million by the end of 2028, growing at a CAGR of XX% between 2018 and 2028. This report provides detailed historical analysis of global market for Biosimilar Monoclonal AntibodiesContinue reading “Biosimilar Monoclonal Antibodies Market Size, Share, Demand, Challenges, Growth And Research In Medical Sector 2028”
Colposcopes Market Key Highlights, Size, Share, Growth Challenges, Industry Segments, Competitors Analysis & Forecast To 2024
In the context of China-US trade war and global economic volatility and uncertainty, it will have a big influence on this market. Colposcopes Report by Material, Application, and Geography – Global Forecast to 2023 is a professional and comprehensive research report on the world’s major regional market conditions, focusing on the main regions (North America,Continue reading “Colposcopes Market Key Highlights, Size, Share, Growth Challenges, Industry Segments, Competitors Analysis & Forecast To 2024”